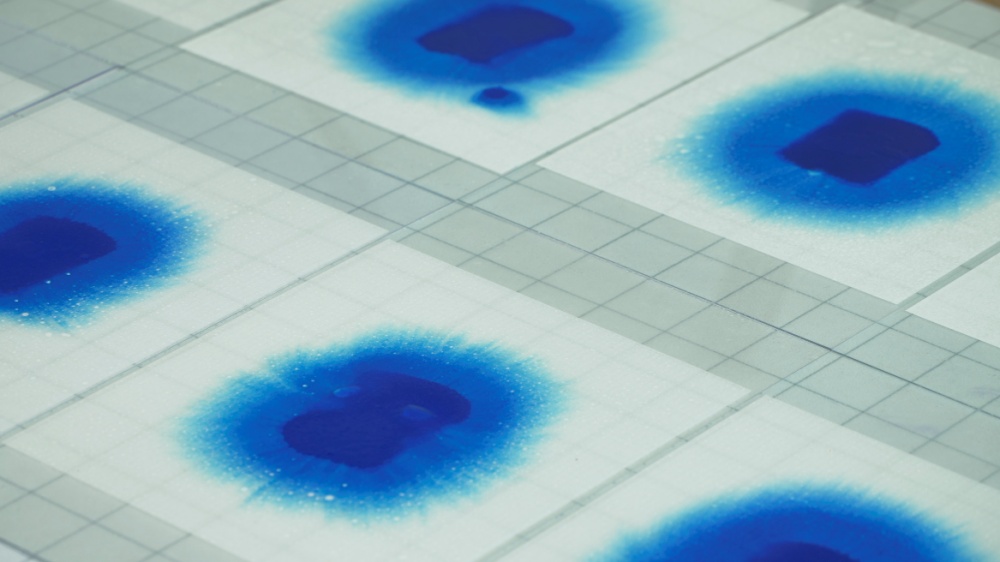
▲ 강운, 물위를 긋다 ©GS칼텍스 예울마루

GS칼텍스 예울마루가 24일부터 3월 30일까지 창작스튜디오 3기 단기입주작가전 ‘강운<파랑>전’을 예술의 섬 장도 전시실에서 개최한다.
이번 전시는 예울마루 창작스튜디오 3기 입주작가 중 단기작가로 선정된 강운 작가의 개인전이다.
강운 작가는 1999년 광주예총 광주예술문화상 신인상을 수상했으며 국립현대미술관, 서울시립미술관, 일본 모리미술관 등에 작품이 소장된 회화작가이다.
포스코 미술관, 사비나 미술관, 전남도립미술관 등에서 개인전 24회, 일본 모리미술관, 광주비엔날레 등에서 그룹전 420여회에 참여한 베테랑 작가이다.
미술계에서 ‘구름 작가’로 불렸던 강운 작가는 30여년 간 실험과 연구를 통해 발전시킨 본인만의 조형어법과 장도에 입주해 느낀 섬 고유의 에너지, 바다의 변화에 따른 심상을 자신만의 시각언어로 표현했다.
전시작품은 약 600여점으로 여수의 365개 섬을 작가 고유의 언어를 통해 시각화 시킨 작품을 전시한다. 예울마루 창작스튜디오 입주 전부터 확고하게 방향성을 잡은 작품으로, 2010년경부터 작업해 온 <물 위를 긋다> 연작도 감상할 수 있다.

화선지에 담채로 표현한 색면추상 작업을 진행한 강운 작가는 섬의 변화무쌍한 자연현상, 보이지 않는 물질, 인지하지 못하는 형상을 색채의 다양한 변화를 활용해 365개 섬에 생명력을 부여했다.
이러한 행위를 통해 작가는 본인과 섬을 연결시켰고, 작가에 의해 생명력을 얻은 섬들은 각자의 색을 발산해 관람객에게 마음의 안식과 치유, 더불어 삶의 긍정적인 방향으로 갈 수 있는 위로의 메시지를 작품을 통해 전달할 예정이다.
‘강운<파랑>전’은 예술의 섬 장도 전시실에서 24일부터 3월 30일까지 열리고 관람 시간은 오전 10시부터 오후 6시까지이며 매주 월요일 휴관이다. 티켓 가격은 1인당 2천원이며, 36개월 미만과 65세 이상 관람자는 무료 입장이 가능하다.
자세한 내용은 예울마루 홈페이지(www.yeulmaru.org)와 전화문의(1544-7669)를 통해 확인할 수 있다.
한편 예울마루는 2022년 3월 창작스튜디오 3기 입주작가를 선정하여 예술의 섬 장도에 창작공간을 제공하고 전시 개최 등 다양한 프로그램을 연계해주며 예술가들의 활동을 지원하고 있다.

